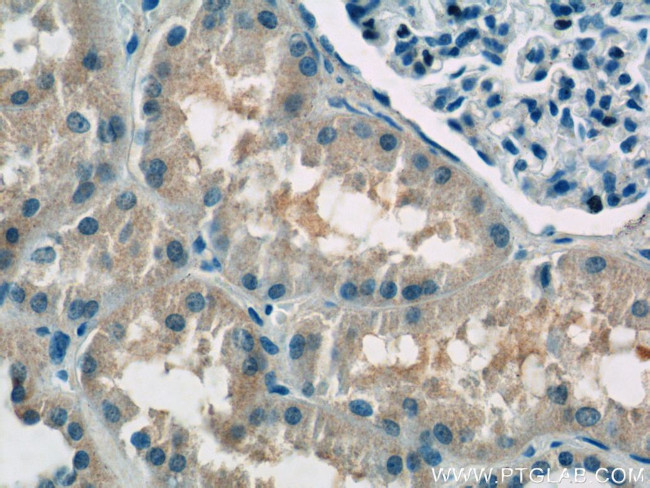
ATP6AP1 Antibody in Immunohistochemistry (Paraffin) (IHC (P))

Search
Proteintech
ATP6AP1 Polyclonal Antibody
{{$productOrderCtrl.translations['antibody.pdp.commerceCard.promotion.promotions']}}
{{$productOrderCtrl.translations['antibody.pdp.commerceCard.promotion.viewpromo']}}
{{$productOrderCtrl.translations['antibody.pdp.commerceCard.promotion.promocode']}}: {{promo.promoCode}} {{promo.promoTitle}} {{promo.promoDescription}}. {{$productOrderCtrl.translations['antibody.pdp.commerceCard.promotion.learnmore']}}
产品信息
15305-1-AP
种属反应
宿主/亚型
分类
类型
抗原
偶联物
形式
浓度
规格
纯化类型
保存液
内含物
保存条件
运输条件
产品详细信息
Immunogen sequence: VPLVLWSSD RDLWAPAADT HEGHITSDLQ LSTYLDPALE LGPRNVLLFL QDKLSIEDFT AYGGVFGNKQ DSAFSNLENA LDLAPSSLVL PAVDWYAVST LTTYLQEKLG ASPLHVDLAT LRELKLNASL PALLLIRLPY TASSGLMAPR EVLTGNDEVI GQVLSTLKSE DVPYTAALTA VRPSRVARDV AVVAGGLGRQ LLQKQPVSPV IHPPVSYNDT APRILFWAQN FSVAYKDQWE DLTPLTFGVQ ELNLTGSFWN DSFARLSLTY ERLFGTTVTF KFILANRLYP VSARHWFTME RLEVHSNGSV AYFNASQVTG PSIYSFHCEY VSSLSKKGSL LVARTQPSPW QMMLQDFQIQ AFNVMGEQFS YASDCASFF (45-422 aa encoded by BC000724)
靶标信息
Vacuolar-type H+-ATPase (V-ATPase) is a multisubunit enzyme responsible for acidification of eukaryotic intracellular organelles. V-ATPases pump protons against an electrochemical gradient, thereby synthesizing ATP. A peripheral V1 domain, which is responsible for ATP hydrolysis, and an integral V0 domain, which is responsible for proton translocation, compose the V-ATPase. Nine subunits (A-H) make up the V1 domain and five subunits (a, d, c, c' and c"") make up the V0 domain. ATP6AP1 (ATPase, H+ transporting, lysosomal accessory protein 1), also known as 16A, CF2, Ac45, XAP3, ATP6S1, VATPS1 (vacuolar ATP synthase S1 accessory protein) or ATP6IP1, is a type I transmembrane, V-ATPase accessory protein that is predominantly expressed in endocrine and neuronal cells. ATP6AP1 is responsible for targeting the V-ATPase enzyme to specialized complex vacuolar systems. Via its cytoplasmic tail, ATP6AP1 interacts with subunits of the V0 domain. The disruption of this interaction in osteoclasts results in impaired bone resorption, suggesting an important role for ATP6AP1 in proper osteoclastic bone resorption.
仅用于科研。不用于诊断过程。未经明确授权不得转售。
生物信息学
蛋白别名: ATPase, H+ transporting, lysosomal (vacuolar proton pump), subunit 1; ATPase, H+ transporting, lysosomal accessory protein 1; ATPase, H+ transporting, lysosomal interacting protein 1; C7-1 protein; epididymis secretory sperm binding protein; H-ATPase subunit; MGC129781; Protein C7-1; Protein XAP-3; unnamed protein product; V-ATPase Ac45 subunit; V-ATPase S1 accessory protein; V-ATPase subunit Ac45; V-ATPase subunit S1; V-type proton ATPase subunit S1; vacuolar ATPase subunit S1; vacuolar H+ ATPase accessory subunit 1; Vacuolar proton pump subunit S1; X-associated protein 3
基因别名: 16A; AC45; AI316502; ATP6AP1; ATP6IP1; ATP6S1; AW108110; C7-1; CF2; mFLJ00383; VATPS1; XAP-3; XAP3
UniProt ID: (Human) Q15904, (Mouse) Q9R1Q9, (Rat) O54715
Entrez Gene ID: (Human) 537, (Mouse) 54411, (Rat) 83615